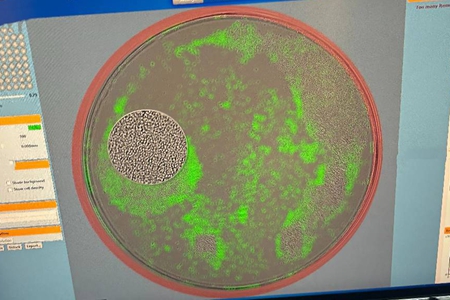

-
產(chǎn)業(yè)一線|從篩選一粒細(xì)胞到“拿掉”化療,...
細(xì)胞培養(yǎng)器 中新經(jīng)緯王玉玲攝 推動實(shí)現(xiàn)胃癌“去化療” 從一顆細(xì)胞,到最終治病救...
2025-11-21 13:45:39產(chǎn)業(yè)一線|車間里的機(jī)器人“同事”,讓汽車...
2025-11-21 11:52:43產(chǎn)業(yè)一線|中東的嘮嗑生意是這樣做成的
”宋朋亮表示,公司深入中東市場后很快實(shí)現(xiàn)盈利,帶動社交業(yè)務(wù)線在2018年5月扭虧為盈。...
2025-11-06 15:38:57產(chǎn)業(yè)一線|“做航線像下棋一樣”,“海上滴...
(付健青)“2023年紅海航道受阻的時候,我們的船只剛好就在中心……”在位于福建省福州...
2025-09-12 11:01:41產(chǎn)業(yè)一線|烈日炎炎!這些硬核防曬美白你做...
近日,護(hù)膚品牌谷雨研發(fā)負(fù)責(zé)人李安章從專業(yè)角度支招,向中新經(jīng)緯產(chǎn)業(yè)一線欄目講述防曬...
2025-08-23 18:00:13產(chǎn)業(yè)一線|將上億元水下機(jī)器人價格打下來,...
(魏薇)在工作人員的操控下,一臺黃色的水下機(jī)器人“游”進(jìn)水中、打開前燈、逐漸下沉。...
2025-08-22 17:32:32產(chǎn)業(yè)一線丨一臺機(jī)器頂80人!“慧”種番茄這...
傳化農(nóng)業(yè)技術(shù)創(chuàng)新中心主任榮松介紹育種實(shí)驗(yàn)室中的種子 中新經(jīng)緯 攝 謝徑安聚焦番茄...
2025-07-09 08:32:48產(chǎn)業(yè)一線丨實(shí)探!無人機(jī)撒肥,3分半鐘10畝地
(熊思怡)一陣“微型龍卷風(fēng)”后,一架載有50公斤尿素顆粒的無人機(jī)騰空而起,飛向大片剛...
2025-03-13 07:42:45本網(wǎng)站所刊載信息,不代表中新經(jīng)緯觀點(diǎn)。 刊用本網(wǎng)站稿件,務(wù)經(jīng)書面授權(quán)。
未經(jīng)授權(quán)禁止轉(zhuǎn)載、摘編、復(fù)制及建立鏡像,違者將依法追究法律責(zé)任。
[京B2-20230170] [京ICP備17012796號-1]
[互聯(lián)網(wǎng)新聞信息服務(wù)許可證10120220005] [互聯(lián)網(wǎng)宗教信息服務(wù)許可證:京(2022)0000107]
違法和不良信息舉報電話:18513525309 報料郵箱(可文字、音視頻):zhongxinjingwei@chinanews.com.cn
Copyright ©2017-2025 jwview.com. All Rights Reserved
北京中新經(jīng)聞信息科技有限公司